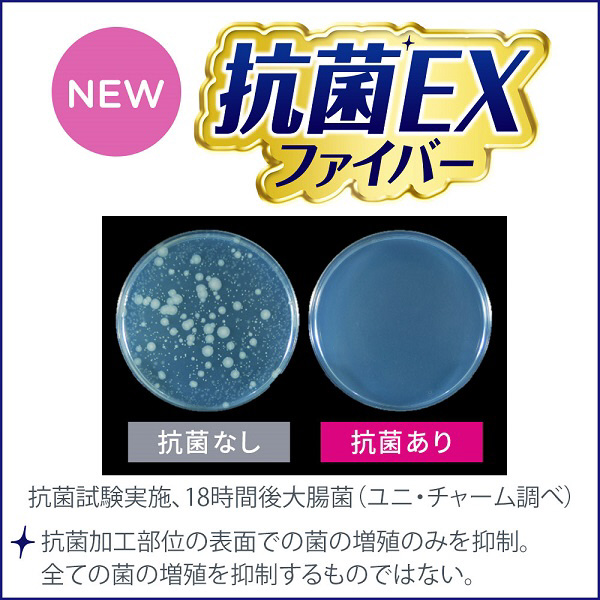

ユニチャーム
【ウェーブ】共通替シート フレッシュグリーンの香り 8枚
からめる密着ファイバーと、舞い上げブロックシートが、舞い上げずからめとって離さない!グリーンの香り
| ソフマップ特価 | ¥496(税込)消費税¥45税抜¥451 |
|---|---|
| ソフマップポイント | 50ポイントサービス (税込価格の10%分) |
| 在庫 |
在庫あり
通常24時間以内に出荷 お一人様10点まで |
| 送料 |
¥550(税込)
送料グループ:通常商品
|
| お支払い方法 |
ご利用いただけるPay払い |